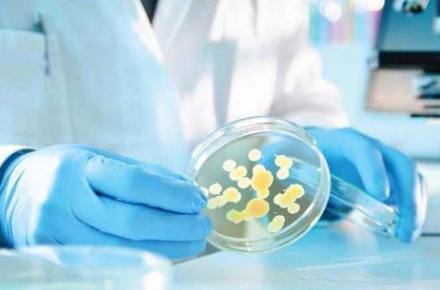

За 9 місяців поточного року у Житомирській області не було зареєстровано жодного спалаху кишкової інфекції, також зафіксували значно менше випадків ботулізму, ніж за аналогічний період минулого 2019 року.
Такі дані наводить пресслужба ГУ Держпродспоживслужби в Житомирській області в інформації щодо епідситуації в області за 9 місяців 2020 року.
«За 9 місяців 2020 року спалахів гострої кишкової інфекції на території Житомирської області не реєструвалось. За аналогічний період 2019 року було зареєстровано 4 спалахи, де перехворіло 52 особи, в т.ч. 16 дітей до 17 років. З початку 2020 року в області зареєстровано 2 побутових випадки ботулізму, внаслідок яких постраждало 2 дорослих осіб (с. Великі Деревичі Любарського району та м. Бердичів). В минулому році було зареєстровано 9 таких випадків з 9-ма постраждалими. Причинами отруєння стали продукти домашнього виготовлення: консервовані гриби домашнього виготовлення та риба річкова в’ялена», - йдеться у повідомленні.
Крім того, за даними Держпродспоживслужби в Житомирській області, в поточному році зареєстровано 2 випадки отруєння грибами в Любарському районі (села Коростки та Гринівці), внаслідок яких постраждало 2 дорослих осіб. За аналогічний період минулого року випадків отруєння не було.
Як повідомляв Житомир.info, 2 серпня 2019 року управління ЦЗН Житомирської ОДА повідомляло про випадок отруєння грибами у Коростені, тоді госпіталізували літню жінку. А 29 липня 2019 року до реанімаційного відділення Бердичівської міськлікарні потрапив підліток, який поїв грибів разом з дідом і бабою. Однак, як повідомили згодом Житомир.info у Житомирському обласному лабораторному центрі, діагноз «отруєння грибами» в обох цих випадках не підтвердився. У листопаді 2019 ДСНС в області повідомляло про отруєння грибами подружжя з села Ігнатпіль Овруцького району.
























